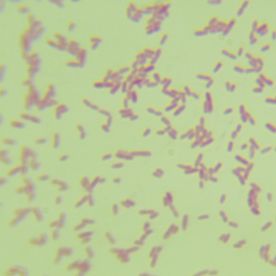
产品封面图

万千商家帮你免费找货
0 人在求购买到急需产品
- 详细信息
- 文献和实验
- 技术资料
- 库存:
100
- 英文名:
Cryptococcus laurentii
- 保质期:
不建议长期存放
- 供应商:
优利科(上海)生命科学有限公司
- 保存条件:
2-8℃
- 规格:
冻干粉
罗伦隐球酵母菌种简介:
| 菌种名称 |
罗伦隐球酵母 |
| 规格 |
冻干粉 |
| 生长条件 |
30℃;24-48h;好氧 |
| 菌种主要应用 |
研究;教学 |
罗伦隐球酵母大小:1-2mm 形状:圆形 边缘:整齐 透明度:不透明 颜色:乳白色 隆起度:中间凸起 表面:明亮光滑 质地:湿润易挑起
保存条件:2-8℃
安瓿管开封步骤:


罗伦隐球酵母传代方法:①准备1支含有5~10mL液体培养基的试管和2个平板;②安全柜中打开,用酒精灯灼烧顶部,后迅速滴上无菌水使之破裂,随后用镊子将其敲碎;③吸取0.5mL液体培养基打入冻干管,充分溶解后重新打回液体试管中,混匀;④吸取0.2mL菌悬液打入平板中,涂布均匀,重复两次获得两个平板;⑤将液体试管和平板全部置于上述培养条件下培养,菌种长出即可使用。
培养基:YM培养基(YM):酵母膏 3.0g,麦芽提取物 3.0g,葡萄糖 10.0g,蛋白胨 5.0g,琼脂 20.0g(液体培养基不含),蒸馏水 1.0L,pH 6.2±0.2。121℃,15min灭菌。
注意事项
1 微生物菌种应保存于低温、清洁和干燥的地方,室温放置时间过长会导致菌种衰退;
2 菌种操作在无菌条件下进行,接种完毕应该灭菌再做丢弃处理;
3 斜面菌种和穿刺菌种保存时间通常为3-6个月,应根据菌种状况及时结转;冻干粉保存时间通常是2-25年;甘油菌保存时间为2-5年。

活化步骤图:

罗伦隐球酵母相关产品:
| 潮湿纤维单胞菌 | |
| 产黄纤维单胞菌 | 利用纤维素能力强 |
| 黄色短杆菌 | 产谷氨酸、抗噬菌体 |
| 球型芽孢杆菌 | 杀蚊子 |
| 巨大芽孢杆菌 | 生产细菌肥料 |
| 地衣芽孢杆菌 | 耐高温淀粉酶 |
| 枯草芽孢杆菌 | |
| 大肠埃希氏菌 | |
| 枯草芽孢杆菌 | |
| 金黄色葡萄球/菌金黄色亚种 | 抗生素测定菌株 |
| 铜绿假单胞菌 | 抗微生物防腐剂检测质控菌株 |
| 大肠埃希氏菌 | 质控菌株 |
| 铜绿假单胞菌 | 抗生素敏感试验质控菌株 |
| 金黄色葡萄球/菌金黄色亚种 | 抗生素敏感试验质控菌株 |
| 大肠埃希氏菌 | 抗生素敏感试验质控菌株 |
| 嗜水气单胞菌 | |
| 粪产碱菌 | |
| 微黄八叠球菌 | |
| 动物双歧杆菌 | 乳制品发酵;食品饮料 |
| 荚膜红细菌 | 厌氧,在钨丝灯下培养 |
风险提示:丁香通仅作为第三方平台,为商家信息发布提供平台空间。用户咨询产品时请注意保护个人信息及财产安全,合理判断,谨慎选购商品,商家和用户对交易行为负责。对于医疗器械类产品,请先查证核实企业经营资质和医疗器械产品注册证情况。
 文献和实验
文献和实验新生隐球菌及其检验是微生物检验考试复习需要了解的知识,医学|教育网搜集整理了相关内容与考生分享。 新生隐球菌(CuyitococcusNeofonmans)又名溶组织酵母菌(TorulaHistolytica),是土壤,鸽类,牛乳、水果等的腐生菌,也可存在人口腔中,可侵犯人和动物,一般为外源性感染,但也可能为内源性感染,对人类而言,它通常是条件致病菌。 本菌在组织液或培养物中呈较大球形,直径可达5-20um,菌体周围有肥厚的荚膜,折光性强,一般染料不易着色难以发现,称隐球菌,用墨汁阴性
新生隐球菌及其检验是微生物与寄生虫检验考试复习需要了解的知识,医学|教育网搜集整理了相关内容与考生分享。 新生隐球菌(CuyitococcusNeofonmans)又名溶组织酵母菌(TorulaHistolytica),是土壤,鸽类,牛乳、水果等的腐生菌,也可存在人口腔中,可侵犯人和动物,一般为外源性感染,但也可能为内源性感染,对人类而言,它通常是条件致病菌。 本菌在组织液或培养物中呈较大球形,直径可达5-20um,菌体周围有肥厚的荚膜,折光性强,一般染料不易着色难以发现
新型隐球菌(Crytococcus Neofonmans )又名溶组织酵母菌(Torula Histolytica ),是土壤,鸽类,牛乳、水果等的腐生菌,也可存在人口腔中,可侵犯人和动物,一般为外源性感染,但也可能为内源性感染,对人类而言,它通常是条件致病菌。 本菌在组织液或培养物中呈较大球形,直径可达5-20um,菌体周围有肥厚的荚膜,折光性强,一般染料不易着色难以发现,称隐球菌,用墨汁阴性显影法镜检,可见到透明荚膜包裹着菌细胞